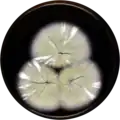
Aspergillus waksmanii growing on MEAOX plate

Aspergillus waksmanii
| Aspergillus waksmanii | |
|---|---|
| Scientific classification | |
| Kingdom: | Fungi |
| Division: | Ascomycota |
| Class: | Eurotiomycetes |
| Order: | Eurotiales |
| Family: | Aspergillaceae |
| Genus: | Aspergillus |
| Species: | A. waksmanii
|
| Binomial name | |
| Aspergillus waksmanii | |
| Type strain | |
| NRRL 179[1] | |
Aspergillus waksmanii is a homothallic species of fungus in the genus Aspergillus which has been isolated from soil from New Jersey in the United States.[1][2][4] It is from the Fumigati section.[5] Several fungi from this section produce heat-resistant ascospores, and the isolates from this section are frequently obtained from locations where natural fires have previously occurred.[6] Aspergillus waksmanii produces apolar indoloterpenes.[7]
Growth and morphology
A. waksmanii has been cultivated on both Czapek yeast extract agar (CYA) plates and Malt Extract Agar Oxoid® (MEAOX) plates. The growth morphology of the colonies can be seen in the pictures below.
-
 Aspergillus waksmanii growing on CYA plate
Aspergillus waksmanii growing on CYA plate -
Aspergillus waksmanii growing on MEAOX plate
Aspergillus waksmanii growing on MEAOX plate
References
- ^ a b c "Aspergillus waksmanii". www.uniprot.org.
- ^ a b "www.mycobank.org".
{{cite journal}}: Cite journal requires|journal=(help) - ^ Hubka, V; Peterson SW; Frisvad JC; Yaguchi T; Kubátová A; Kolařík M. 2013. Aspergillus waksmanii sp. nov. and Aspergillus marvanovae sp. nov., two closely related species in section Fumigati. International Journal of Systematic and Evolutionary Microbiology. 63:783-789
- ^ Hubka, V.; Peterson, S. W.; Frisvad, J. C.; Yaguchi, T.; Kubatova, A.; Kolarik, M. (12 November 2012). "Aspergillus waksmanii sp. nov. and Aspergillus marvanovae sp. nov., two closely related species in section Fumigati". International Journal of Systematic and Evolutionary Microbiology. 63 (Pt 2): 783–789. doi:10.1099/ijs.0.047076-0. PMID 23148097.
- ^ Frisvad, J.C.; Larsen, T.O. (2016). "Extrolites of Aspergillus fumigatus and Other Pathogenic Species in Aspergillus Section Fumigati". Frontiers in Microbiology. 6: 1485. doi:10.3389/fmicb.2015.01485. PMC 4703822. PMID 26779142.
- ^ Samson, R.A.; Hong, S.; Peterson, S.W.; Frisvad, J.C.; Varga, J. (2007). "Polyphasic taxonomy of Aspergillus section Fumigati and its teleomorph Neosartorya". Studies in Mycology. 59: 147–203. doi:10.3114/sim.2007.59.14. PMC 2275200. PMID 18490953.
- ^ Frederic, Lamoth; William J., Steinbach (2016). Advances in Aspergillus fumigatus pathobiology. Frontiers Media SA. ISBN 978-2-889-19789-7.
Further reading
- Frank-Kamenetskaya, Olga V.; Panova, Elena G.; Vlasov, Dmitry Yu (2015). Biogenic—Abiogenic Interactions in Natural and Anthropogenic Systems. Springer. ISBN 9783319249872.